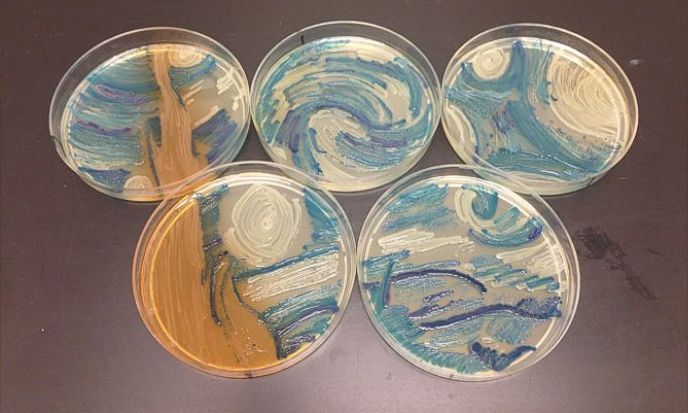
科學家的另類藝術:細菌作畫

當前位置: Language Tips> 雙語新聞
Scientists Create Van Gogh's 'Starry Night,' Other Artwork Using 'Bacteria as Paint'
If you think scientists can't be artsy, think again.
如果你覺得科學家沒有藝術氣息,那你就錯了。
The American Society of Microbiologists (ASM) recently held its first "Agar Art" contest and received 85 submissions of artwork all created by microbiologists "using bacteria as paint and agar and a petri dish as a canvas," according to Emily Dilger, ASM's public outreach manager. Agar is a "jelly-like substance" that bacteria eat and grow on, Dilger explained.
美國微生物學家協會(American Society of Microbiologists,ASM)最近舉辦了第一屆“瓊脂藝術”大賽,據ASM公關經理艾米麗?迪爾格(Emily Dilger)介紹,大賽共收到85份由微生物學家創作的參賽作品。它們都是“以細菌為顏料,以瓊脂和一個培養皿為畫布”完成的。迪爾格解釋稱,瓊脂是一種“膠狀物質”,細菌可以通過吞食瓊脂生長。
The microscopic masterpieces included a recreation of Vincent van Gogh's "The Starry Night" by Missouri microbiologist Melanie Sullivan. She used several types of bacteria to produce the various colors, including bacteria that is "a common cause of lower urinary tract infections" and a bacterium that can cause infections including pneumonia and meningitis, according to her description of her piece.
這些用顯微鏡才能觀察的作品中,來自密蘇里州的微生物學家梅勒妮?沙利文(Melanie Sullivan)的作品復刻了梵高的《星空》。她的作品描述介紹稱,她用多種類型的細菌制作出多種顏色,包括“引起下尿路感染的常見病原菌”和一種可導致肺炎和腦膜炎的細菌。
"Because a lot of these bacteria can have dangerous implications, we made sure all the submissions had to come from a member of the society," ASM marketing coordinator Chaseedaw Giles told ABC News. "Lots of safety precautions have to be taken, especially in properly storing and disposing these cultures, so we didn't just want random people playing around with bacteria."
ASM市場部協調員查西道·賈爾斯(Chaseedaw Giles)告訴美國廣播公司新聞(ABC News):“因為這些細菌中有很多具有危險性,所以我們確保所有參賽作品都是來自協會成員。我們做了很多安全防范措施,尤其在這些培養菌的妥善保存和處理方面,所以我們可不是讓隨便某個人來
擺弄細菌。”

The "Agar Art" contest ran through this summer, and the winners were announced in late September after a panel of five judges - including professors and an artist - reviewed the submissions based on "creativity, design, and presentation," Giles said.
賈爾斯介紹,“瓊脂藝術”大賽持續了一個夏天,最后由包括微生物學教授和一名藝術家在內的五名評委經過認真的審查,作品的“創造性、設計和展示”于9月份評選出最后的獲勝者。

The top three winners included artistic renditions of neurons, a map of New York City and the harvest season.
前三名作品分別是神經元的藝術再現、紐約市地圖和收獲的季節。

"One of the coolest things about the contest has been reading the descriptions from the scientists of all the ways they grew these different bacteria and all the trial-and-error they had to do," Giles said. "Many talked about the number of tries it took them to get certain patterns and intensity of color. Everyone did something different to come up with their final product."
賈爾斯說:“這次比賽最酷的地方之一就是閱讀各位科學家關于如何培養這些不同的細菌以及他們反復試驗的過程描述。很多人描述了自己為了得到特定的圖案和色彩飽和度反復嘗試了多少次。每個人都為了最后的作品嘗試了很多不同的事情。”
The contest has also dispelled a long-held stereotype that scientists can't be artistic and vice versa.
本次比賽也打破了一直以來人們覺得科學家不懂藝術,藝術家不懂科學的成見。

"I think this is a great example of the beautiful things that can come out of not putting people in certain boxes and defining them by a strict label," Giles said. "It shows art and science can be married together."
賈爾斯說:“跳出原有的框架和避免嚴格的標簽定義能夠產生美好的事物,我覺得這次比賽就是一個很好的例子。它展現了藝術和科學可以很好的融合在一起。”
Vocabulary
microbiologist:微生物學家
agar: 瓊脂
petri dish:皮氏培養皿
microscopic:用顯微鏡可見的
pneumonia:肺炎
meningitis:腦膜炎
rendition:演繹
trial-and-error:(為求完善的)反復試驗
英文來源:ABC News
譯者:張卉
審校&編輯:劉明
上一篇 : 小貝將在七大洲踢七場足球賽
下一篇 : 習近平訪英成果清單
關注和訂閱
電話:8610-84883645
傳真:8610-84883500
Email: languagetips@chinadaily.com.cn